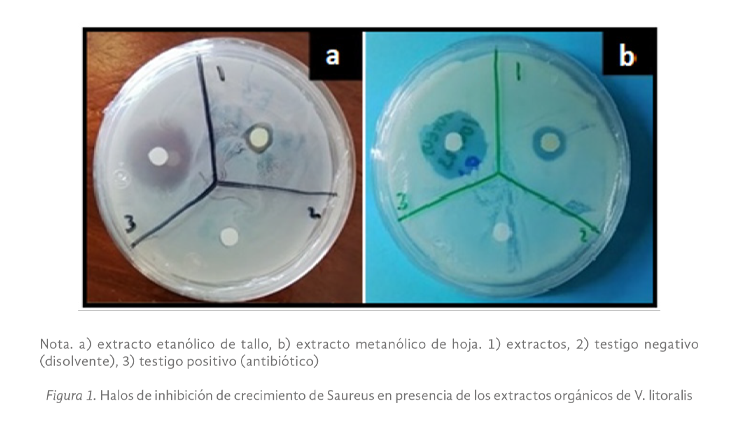
Imagen05

Estudio del Potencial Antimicrobiano de Extractos Orgánicos de Verbena litoralis
Study of Antimicrobial Potential Of Verbena litoralis Organic Extracts
 https://orcid.org/0000-0002-4743-9112
https://orcid.org/0000-0002-4743-9112
Maldonado-Fernández, Alisa Patricia apmfdez@gmail.com Escuela de Ciencias Químicas, Universidad Autónoma de Chiapas, Ocozocoautla de Espinosa, Chiapas México.
 https://orcid.org/0009-0005-7591-3204
https://orcid.org/0009-0005-7591-3204
Castillo-Valencia, Román romancastillo2411@gmail.com Escuela de Ciencias Químicas, Universidad Autónoma de Chiapas, Ocozocoautla de Espinosa, Chiapas México.
 https://orcid.org/0009-0006-4809-508X
https://orcid.org/0009-0006-4809-508X
Salgado-Gutiérrez, María Catalina maria.sg@tuxtla.tecnm.mx Tecnológico Nacional de México, Campus Tuxtla. Tuxtla Gutiérrez, Chiapas, México.
 https://orcid.org/0009-0004-1974-2474
https://orcid.org/0009-0004-1974-2474
DOI: https://doi.org/10.31644/IMASD.35.2024.a02
Fecha de recepción: 11 de abril 2023
Fecha de aceptación: 13 de octubre 2023
Fecha de publicación: 01 de febrero 2024
Resumen
Verbena litolaris (V. litoraris) es una planta usada en la medicina tradicional de México por la población pluricultural y ha mostrado ser efectiva para aliviar síntomas del resfriado, dolor de estómago, fiebre, diarrea, entre otros. Los reportes científicos de su potencial farmacológico son limitados, por lo que en este estudio se determinó el potencial antimicrobiano de extractos de V. litoraris sobre cepas patógenas responsables de infecciones gastrointestinales. La preparación de los extractos crudos orgánicos fue por sonicación y el efecto de inhibición del crecimiento bacteriano se realizó mediante el método de difusión en discos y la concentración mínima inhibitoria de los extractos se obtuvo a través de microdilución en placa. También se hizo el análisis fitoquímico mediante Cromatografía en Capa Fina (CCF) y espectrofotometría de luz visible. El extracto metanólico de hoja y los extractos etanólico y cetónico de tallo de V. litolaris evidenciaron un efecto positivo de inhibición del crecimiento en todas las cepas evaluadas. E. coli fue la cepa con mayor sensibilidad a los componentes del extracto etanólico de tallo con una concentración mínima inhibitoria (CMI) de 5 mg/mL. El extracto metanólico de hoja de V litolaris presentó la mayor concentración de fenilpropanoides con 11.75 + 0.03 µg Eq rutina/mL. Este es el primer reporte de la presencia de cumarinas, antronas y antraquinonas en V. litoralis y con nuestros resultados se contribuye para validar su uso como una alternativa para inhibir el crecimiento de las cepas evaluadas.
Palabras clave: Antibacteriano; Verbena litolaris; Fitoquímicos; Infecciones gastrointestinales
-Abstract-
Verbena litolaris is a plant used in traditional medicine in Mexico by the multicultural population and has shown to be effective in relieving cold symptoms, stomach ache, fever, diarrhea, among others; Scientific reports of its pharmacological potential are limited, so in this study the antimicrobial potential of extracts from V. litoraris on pathogenic strains responsible for gastrointestinal infections was determined. The crude organic extracts were prepared by sonication and the bacterial growth inhibition effect was performed using the disk diffusion method and the minimum inhibitory concentrations of the extracts was obtained through plate microdilution. Phytochemical analysis was also done by Thin Layer Chromatography (TLC) and visible light spectrophotometry. The methanolic leaf extract and the ethanolic and ketonic extracts of stem from V. litolaris showed a positive effect of inhibition of growth in all the strains evaluated, E. coli was the strain with the highest sensitivity to the components of the ethanolic stem extract with a minimum inhibitory concentration (MIC) of 5 mg/mL. The methanolic extract leaf from V litolaris presented the highest concentration of phenylpropanoids with 11.75 + 0.03 µg Eq rutin/mL. This is the first report of the presence of coumarins, anthrones and anthraquinones in V. litoralis and with our results we contribute to validating their use as an alternative to inhibit the growth of the evaluated strains.
Keywords: Antibacterial, Verbena litolaris, Phytochemicals, Gastrointestinal infections